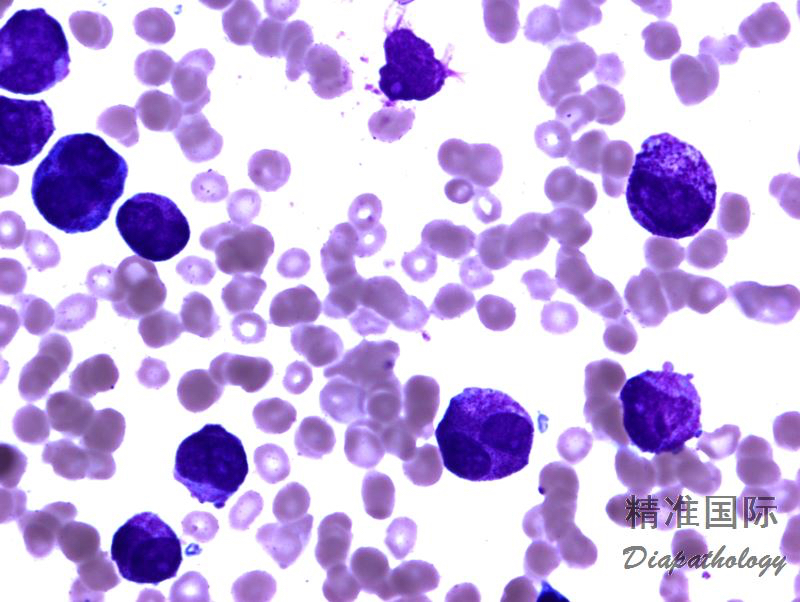

急性早幼粒细胞白血病伴 PML-RARA
Acute promyelocytic leukaemia with PML-RARA
概述:
急性髓系白血病伴 t(15;17)(q24.1;q21.2)是一种以异常早幼粒细胞增生为主的急性髓系白血病,形态学上可分为多颗粒型(经典型)和微小颗粒型或少颗粒型(变异型)。形态学相当于 FAB 分类的 M3(APL) 及其变异型。此病对 ATRA 敏感,有潜在治愈的可能性。
诊断要点:
- 约占急性髓系白血病的 5-8%,可发生于任何年龄,但以多见于中年。常并发弥散性血管内凝血,是导致早期死亡的主要原因,故及时诊断和治疗极其重要。
- 外周血:经典型病例白细胞通常减低或无显著增高,表现为贫血,血小板常不对称性地显著减少。偶见异常的早幼粒细胞,体积大,直径为正常红细胞的 2-3 倍。胞浆内充满粉色至紫色的大颗粒,有时能见到胞浆内束状的 Auer 小体和巨大的颗粒;无高尔基区。核型可呈现圆形、卵圆形、肾性或双叶,但有时胞浆内的巨大颗粒可致核形不清楚。少颗粒变异型急性早幼粒细胞白血病白细胞常显著增高,异常的特征性的早幼粒细胞比经典型多见,很多为双叶核,包浆无颗粒或细小的粉尘状的颗粒,但很多病例总是很找到少数含有明显颗粒或束状 Auer 小体的早幼粒细胞。
- 骨髓细胞学:细胞显著增多,母细胞相对较少,常<20% (不影响对此病的定义和诊断),主要细胞为异常的早幼粒细胞,细胞常可表现为颗粒丰富的早幼粒细胞或少颗粒、双叶核的早幼粒细胞伴有不同程度的颗粒丰富的细胞,在上述两种类型中常常可见异常的早幼粒细胞伴有束状或捆状的 Auer 小体,也可见到有单根 Auer 小体的原始细胞。正常成熟的粒细胞显著减少,红细胞和巨核细胞常减少,但形态正常。
- 骨髓活检:细胞密度常显著增高,伴有形态较一致的异常早幼粒细胞浸润,白血病细胞有典型的特征,塑料包埋切片中表现为有明显的大颗粒充满胞浆,并遮盖细胞核,核常为圆形或双叶状,具有一个突出的核仁。变异型急性早幼粒细胞白血病,异常早幼粒细胞颗粒常明显减少或颗粒不明显,核常呈双叶。在石蜡切片中上述特征不容易辨认。
- 细胞化学染色:几乎所有白血病早幼粒细胞(经典型和微小颗粒型)总是 MPO 强阳性。单核细胞只是弱阳性或阴性,有助与微小颗粒型鉴别。
- 免疫表型:HLA-DR、CD34. CD11a、CD11b、CD18 低表达或不表达,均一的强表达 CD33,CD13 表达强弱不等。很多病例表达 CD117,但有时表达较弱;CD15. CD65 不表达或微弱表达,CD64 常有表达。10%病例表达 CD56,其预后较差。形态学少颗粒者常表达 CD34 和 CD2(至少部分细胞表达)。MPO 强阳性 (流式、免疫组化),有的病例非特异性酯酶可为弱阳性(粗颗粒型)。
- 遗传学:t(15;17)(q24.1;q21.2)形成融合基因 PML-RARA。少数病例只有 PCR 法可检测 PML-RARA 融合基因,但传统的细胞遗传学方法不能检测到相应的染色体异常,可能为复杂性染色体异常同时包含 15、17 号染色体,并有多余染色体或无法识别的微小 RARA 片段插入 PML 基因引起基因融合。40%病例可伴有其他细胞遗传学异常,其中最常见的是+8(发生率 10-15%)。35-45%的病例发生 FLT3 突变,常表现为高白细胞计数和微小颗粒变异型。 除 t(15;17)(q24.1;q21.2)外,其他染色体与 17 号染色体异位可引起形态学类似 APL 的白血病,这些变异型染色体异位包括 t(11;17)(q13.4;q21.2) NUMA1-RARA、t(5;17)(q35;q21.2)NPM1-RARA、t(11;17)(q23.2;q21.2)ZBTB12-RARA、t(17;17)(q11.2;q21.2) STAT5B-RARA,其中后两种变异型异位对全反式维甲酸治疗反应差。t(11;17)(q23.2;q21.2)ZBTB12-RAR 的形态学常表现为规则细胞核,很多颗粒,但无 Auer 小体;t(5;17)(q35;q21.2)NPM1-RARA 常表现为多颗粒细胞和少量少颗粒细胞,光镜下无 Auer 小体,此变异型对维甲酸治疗有反应。

鉴别诊断:
急性单核细胞白血病 :微小颗粒变异型 APL 外周血白细胞计数增高,含大量白血病细胞,其分叶核和胞浆细小不明显的颗粒,与异常单核细胞有些相似。仔细找寻含 Auer 小体的细胞及细胞化学染色和免疫分型有助与急性单核细胞白血病相鉴别。
预后:
APL 对维甲酸和三氧化二砷治疗特别敏感,预后良好。
← 髓系肉瘤 急性原巨核细胞白血病 →
